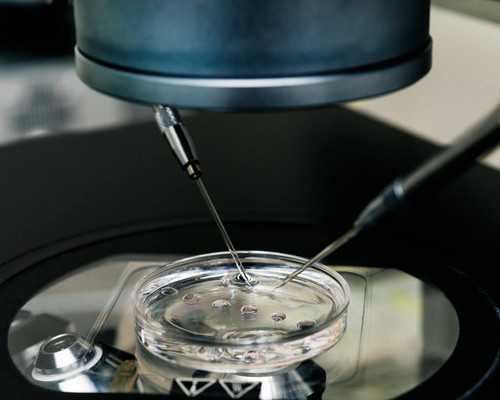
国内供卵试管的步骤, 泰国三代试管筛查技术解读 让您的孩子远离遗传病

是什么,是女人孕育胚胎的一个“小房子”,是对于女人而言,极其重要的一个器官。若是女性不好好爱惜自己的身体健康,或者,那么一些疾病都会找上你的。因为近几年以来,疾病的患者是越来越多,且让一些女性朋友早早离开了这个美丽的世界。虽然,宫颈问题不一......

囊胚5AA是什么质量的,率高吗?有的试管妈妈听说囊胚的等级质量直接与试管婴儿移植能不能直接挂钩,其实小编觉得这种说法并不是没有道理的,因为越优质的囊胚着床率以及率便要高一点,但是很多女性对“5aa囊胚质量怎么样,率高吗”存有一定的疑问,那么......
近年来,随着科学技术的不断发展,临床诊断技术也不断完善,并在实践中取得了显着的成果,其中助孕括泰国三代试管筛查技术。泰国三代试管技术筛查是一种全新的基因检测技术,可以帮助家长预防和控制宝宝遗传病的风险。泰国三代试管筛查技术是泰国第三代基因技......

泰国试管婴儿的费用一直是许多不孕不育夫妇关注的焦点。那么,泰国试管婴儿到底要多少钱?一次试管是否真的会花费巨大?本文将为您揭示这一问题的答案。首先,要明确的是,泰国试管婴儿的费用并不是一个固定的数字,而是根据多种因素而有所变动。根据市场调研......

受精卵着床发在什么时候?受精卵着床降温发在第几天?着床降温是受精卵着床后出现的症状之一,所以有部分女性朋友会监测基础体温来判断自己是否受孕。那么,受精卵着床降温一般发在第几天呢?下面我们就一起来看看。受精卵着床降温发在第几天着床降温一般发在......

胚胎移植后对睡眠姿势有要求吗?胚胎移植后对患者的睡眠姿势有要求吗?答案是没有任何要求。胚胎是通过非常细的小管子植入腔内,胚胎在内膜定位、黏附、侵入和种植。这个过程并不受到日常活的影响,当然也不会要求特定的睡眠姿势。正常情况下,入睡时是可以调......

未婚试管婴儿孩子要多少钱?条件解释!未婚单身人士做试管婴儿是一个越来越受关注的话题。许多未婚单身人士希望通过试管婴儿实现自己的亲子梦想。然而,试管婴儿孩子的费用一直是人们关注的问题之一。本文将讨论未婚单身试管婴儿的费用及相关费用明细。未婚试......

选择第三代试管婴儿的人群中有很大部分是某些遗传病携带者,而遗传性疾病也分染色体病、单基因遗传病、多基因遗传病和线粒体这4大类,今天这里咱们就来说说比较常见的“单基因遗传病”!单基因遗传病现状单基因遗传病就是由于一个基因突变所导致的遗传性疾病......

三月沐风,空山凝云,在这个春天的三月,昨天也迎来了一年一度的妇女节。昨天,朋友圈里到处都是赞美女人的话:她们是世界上最好的存在,女儿、妻子和母亲。但在现实活中,很多人无法实现做母亲的愿望。经过强烈的治疗,他们仍然没有结果。最后,他们直接借助......

殖专家胡晓伟表示,试管受精的率取决于许多方面,除了实验室条件、技术人员的技术水平外,还取决于患者的年龄、内分泌状况、和卵巢条件以及是否有其他疾病等,这些都是影响率的因素。柚子观点:试管受精的与许多事情有关,所以在患者做试管受精的过程中,我们......